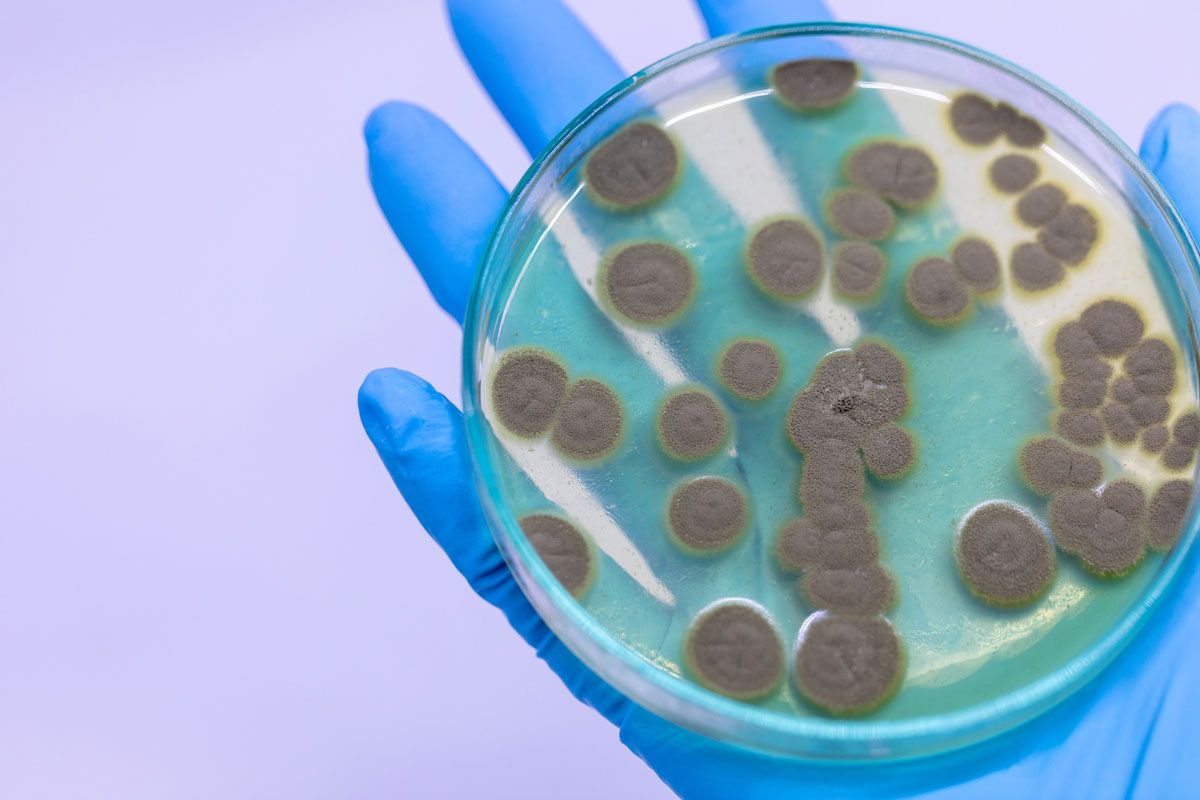

Исследование мира микробиологии через объектив: фотографии в чашке Петри Флеминга

Раздел: Природная галерея